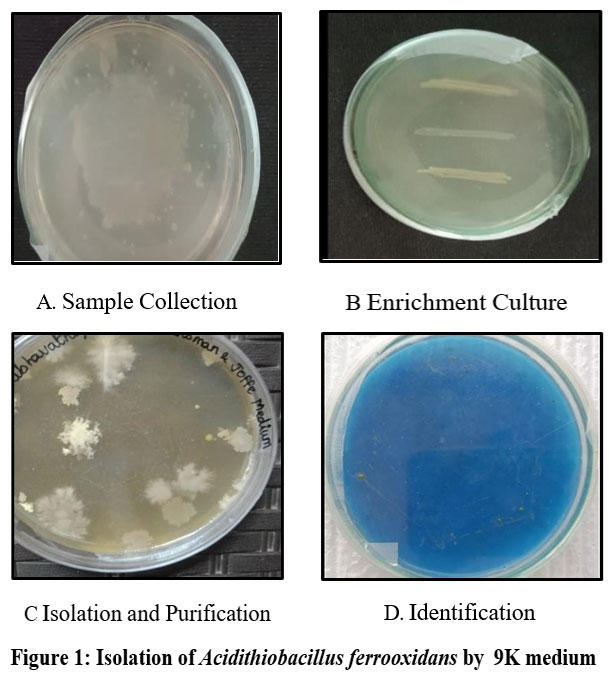

Manuscript accepted on : 02-07-2025
Published online on: 24-09-2025
Plagiarism Check: Yes
Reviewed by: Dr. Sarraa Dhiaa Kasim
Second Review by: Dr. Sonam Sneha
Final Approval by: Dr. Eugene A. Silow
Barkathulla Syed Nazeer
, Vijaya Surya Velu
and Dheepan George*
Deptartment of Microbiology, AVS College of arts and science (Autonomous), Salem India.
Corresponding Author E-mail: dheepanmicro2021@gmail.com
ABSTRACT: To explore the potential of Plant Growth-Promoting Bacteria (PGPB) such as Acidithiobacillus sp. in improving sugarcane tolerance to abiotic stresses like drought, salinity, and nutrient deficiencies, and optimizing carbon supply for sustainable cultivation.1 The use of Plant Growth-Promoting Bacteria (PGPB) has the potential for enhancing agricultural sustainability and productivity. PGPB supports plants in a variety of ways, including nutrient absorption, hormone production, and disease prevention. However, strain variability, formulation and distribution concerns, regulatory barriers, and socioeconomic constraints all offer obstacles to their widespread use. Addressing these challenges requires collaborative efforts from researchers, policymakers, extension workers, and farmers to identify effective PGPB strains, develop stable formulations, navigate regulatory processes, and provide technical support for successful integration into agricultural practices.2 Sugarcane plantlets in tissue culture survived heat stress, suggesting the bioformulation induces abiotic stress tolerance and carbon content was higher in tissue culture-treated, bio-inoculated plants compared to pot culture plants and controls. Despite these challenges, using PGPB has the potential to boost crop yields, minimise chemical inputs, and promote sustainable agriculture, therefore contributing to global food security and environmental stewardship.3 The study To explore the potential of Plant Growth-Promoting Bacteria (PGPB) such as Acidithiobacillus sp. in improving sugarcane tolerance to abiotic stresses like drought, salinity, and nutrient deficiencies, and optimizing carbon supply for sustainable cultivation.1 The use of Plant Growth-Promoting Bacteria (PGPB) has the potential for enhancing agricultural sustainability and productivity. PGPB supports plants in a variety of ways, including nutrient absorption, hormone production, and disease prevention. However, strain variability, formulation and distribution concerns, regulatory barriers, and socioeconomic constraints all offer obstacles to their widespread use. Addressing these challenges requires collaborative efforts from researchers, policymakers, extension workers, and farmers to identify effective PGPB strains, develop stable formulations, navigate regulatory processes, and provide technical support for successful integration into agricultural practices.2 Sugarcane plantlets in tissue culture survived heat stress, suggesting the bioformulation induces abiotic stress tolerance and carbon content was higher in tissue culture-treated, bio-inoculated plants compared to pot culture plants and controls. Despite these challenges, using PGPB has the potential to boost crop yields, minimise chemical inputs, and promote sustainable agriculture, therefore contributing to global food security and environmental stewardship.3 The study suggests that bioformulation induces abiotic stress tolerance and improves carbon supply in sugarcane.
KEYWORDS: Food security; Hormone synthesis; Plant Growth-Promoting Bacteria; Sustainable agriculture
| Copy the following to cite this article: Nazeer B. S, Velu V. S, George D. Investigating the Enhancement of Tolerance to Abiotic Stress and Improvement of Carbon Supply in Sugarcane Using, Acidithiobacillus sp.,. Biotech Res Asia 2025;22(3). |
| Copy the following to cite this URL: Nazeer B. S, Velu V. S, George D. Investigating the Enhancement of Tolerance to Abiotic Stress and Improvement of Carbon Supply in Sugarcane Using, Acidithiobacillus sp.,. Biotech Res Asia 2025;22(3). Available from: https://bit.ly/46RNifl |
Introduction
The cultivation of Saccharum officinarum, commonly known as sugarcane, is vital for global sugar production and bioenergy. However, sugarcane faces numerous challenges, including abiotic stressors such as drought, salinity, and nutrient deficiencies, which cyanobacteria (PGPB) has emerged as a promising strategy to enhance plant growth, improve stress tolerance, and optimize nutrient uptake in various crops, including sugarcane.4 Among the diverse array of PGPB Acidithiobacillus sp have shown potential in promoting plant growth and mitigating abiotic stress effects. Acidithiobacilli are a common group of microorganisms in acidic mines and are active in the degradation of a range of sulfide minerals. Acidithiobacillus ferrooxidans is a Gram-negative, Acidophilic bacterium, which thrives in harsh environments and exhibits a versatile energy metabolism. The most important one is Acidithiobacillus ferrooxidans which is a Gram negative chemolithotropic bacteria.5
In recent decades, the global agricultural sector has faced escalating challenges due to climate change, dwindling natural resources, and increasing demand for food and bio energy. Among the crops vulnerable to these challenges is Saccharum officinarum, or sugarcane, a primary source of sugar and bio ethanol. By harnessing the synergistic interactions among these PGPB, this study aims to explore their collective potential in improving sugarcane tolerance to abiotic stress and optimizing carbon supply, thereby contributing to sustainable sugarcane cultivation and global food security.6 As the global agricultural sector grapples with the dual challenges of ensuring food security and environmental sustainability, there is a pressing need to explore innovative strategies for enhancing crop resilience and productivity.
The intricate interplay between plants and beneficial microorganisms offers a promising avenue for bolstering crop resilience and productivity in the face of mounting environmental challenges. Among the diverse array of beneficial microbes, plant growth-promoting bacteria (PGPB) have garnered significant attention for their ability to enhance nutrient uptake, improve stress tolerance, and stimulate plant growth. Acidithiobacillus sp., are three such PGPB that have shown considerable promise in enhancing the performance of various crops, including sugarcane. By leveraging the unique capabilities of these microbes, this study aims to explore novel strategies for optimizing sugarcane growth and productivity under adverse environmental conditions. Through a comprehensive investigation of the interactions between sugarcane and these PGPB, this research seeks to unlock new insights into microbial-assisted crop management and contribute to the development of sustainable agricultural practices for the future.
Materials and Methods
Isolation of Acidithiobacillus from soil
Collect soil samples from desired locations known to contain sulfur-rich environments, such as mine tailings or acidic soils. Collect samples from different areas to ensure diversity.7 Prepare a sulfur medium such as modified 9K medium or 9K-S according to manufacturer instructions. Sterilize the medium by autoclaving at 121°C for 15-20 minutes. Allow the medium to cool to approximately 45-50°C before use.8 Weigh out a suitable amount of soil sample (e.g., 1 g) and add it to a sterile container with 9 mL of sterile water or saline solution. Mix the soil and solution thoroughly to create a soil suspension. Perform serial dilutions by transferring 1 mL of the soil suspension to 9 mL of sterile water or saline solution, and repeat as necessary to achieve dilutions of 10^-1 to 10^-5.9 Take 100 µL aliquots from appropriate dilutions (e.g., 10^-3 to 10^-5) and spread them evenly onto the surface of selective agar plates (e.g., 9K-S agar) using a sterile loop or spreader. Incubate the plates inverted (lid side down) in an incubator set to 30-37°C for 3-7 days. Using a sterile loop or swab, select individual colonies of Acidithiobacillus from the plates and streak them onto fresh selective agar plates to obtain isolated colonies. Incubate the plates as before and observe for pure cultures of Acidithiobacillus. To confirm the identity of the isolated colonies, perform biochemical tests such as oxidase and catalase tests, as well as molecular techniques like PCR amplification and sequencing of 16S rRNA gene. Once pure cultures are obtained and confirmed, store them at -80°C in suitable cryoprotective medium (e.g., glycerol stock) for long-term storage.10
Tissue culture of sugarcane
Prepare the desired tissue culture medium, such as MS basal medium, according to the manufacturer’s instructions. Adjust the pH of the medium to around 5.8 using a suitable pH buffer. Add agar or a gelling agent to the medium at the recommended concentration (0.7-0.8% w/v) to solidify it. Optionally, supplement the medium with sucrose as a carbon source and plant growth regulators (auxins and cytokinins) at appropriate concentrations to promote shoot initiation and growth.11 Obtain sugarcane explants from healthy and disease-free plants. Nodal segments or meristematic tissue are commonly used. Wash the explants thoroughly under running tap water to remove any debris or contaminants. Surface sterilize the explants by immersing them in a disinfectant solution (70% ethanol or a bleach solution) for a few minutes, followed by rinsing with sterile distilled water. Trim the explants to the desired size (1-2 cm) under sterile conditions using a scalpel or razor blade.12
Inoculation and Culture Initiation
Transfer the sterilized explants to the culture vessels containing the prepared tissue culture medium. Seal the vessels with sterile closures (cotton plugs or plastic caps). Incubate the culture vessels in a growth chamber or incubator with controlled temperature (25-28°C) and light conditions (16-hour photoperiod with fluorescent lights).13 Check the cultures regularly for contamination and growth of new shoots. Subculture the actively growing shoots onto fresh medium every 4-6 weeks to prevent overcrowding and maintain healthy growth. Monitor the cultures for shoot proliferation and elongation, and adjust the growth regulator concentrations as needed to optimize growth.14
Rooting and Acclimatization
Once shoots have developed and reached an appropriate size, induce rooting by transferring them to a rooting medium containing suitable auxins (indole-3-butyric acid, IBA). After roots have developed, carefully transfer the plantlets to pots or trays containing a sterile potting mix. Harden off the plantlets by gradually exposing them to ambient environmental conditions (reduced humidity, increased light intensity) over a period of 1-2 weeks before transferring them to the greenhouse or field.15
Preparation of Bioformulation
Preparation of Bacterial Inoculum
Start by growing the desired bacterial strain in suitable liquid culture medium until they
reach the desired cell density (usually mid-log phase). Harvest the bacterial cells by centrifugation or filtration, and wash them with sterile water or saline solution to remove any residual medium.16
Preparation of Carrier Material
Sterilize the carrier material such as peat, vermiculite by autoclaving or other suitable sterilization method to ensure it is free from contaminants. If using alginate beads, prepare the alginate solution and sterilize it separately before encapsulating the bacterial cells.17
Incorporation of Bacterial Cells into Carrier
Mix the washed bacterial cells with the sterile carrier material in a suitable ratio to achieve the desired cell concentration in the final formulation. Optionally, add nutrients or growth-promoting substances to enhance bacterial viability and activity in the formulation. Ensure thorough mixing to achieve uniform distribution of bacterial cells within the carrier material.18
Addition of Additives
Incorporate any desired additives into the formulation to improve stability, protect the bacterial cells, and enhance performance. Common additives include protective agents such as trehalose, stabilizers such as carboxymethyl cellulose, polyvinyl alcohol, and adhesives such as guar gum, polyacrylic acid.
Adjustment of pH and Moisture Content
Measure the pH of the formulation using a pH meter and adjust it to the desired range of pH 6-8 using sterile solutions of acids or bases as needed. Adjust the moisture content of the formulation to ensure adequate hydration of the bacterial cells without excess moisture that could lead to microbial contamination or degradation of the formulation. Store the bioformulation under appropriate conditions to maintain bacterial viability and stability until use.
Determination of organic carbon in samples by potassium dichromate oxidation methods
The detection method works on the basis of organic matter extraction from the soil. The extraction is again enhanced by addition of chemicals provided in the kit. The colour developed after extraction can be compared with chart provided for estimation of organic carbon content of the soil. The analysis is easy to perform, requires only 15-20 min.19
Results
The isolation of Acidithiobacillus ferrooxidans involves collecting samples from environments rich in sulfide minerals, such as acid mine drainage, coal mines, or bioleaching sites (Fig: 1), (Table: 1).
![]() |
Figure 1: Isolation of Acidithiobacillus ferrooxidans by 9K medium |
Table 1: Bio chemical test for Acidithiobacillus ferrooxidans
| Biochemical Test | Acidithiobacillus ferrooxidans |
| Indole test | (-) ve |
| Methyl Red Test | (+) ve |
| Voges Proskauer (VP) Test | (-) ve |
| Citrate Utilization Test | (+) ve |
| Catalase | (+) ve |
DNA Sequencing
The ITS region of total isolates was successfully amplified by universal primer pairs (ITS1) and generated PCR products with a size of 1496 bp. Bioinformatics analysis, which was performed by comparing the sequence results of the ITS region with sequence data registered in the NCBI nucleotide Blast https://www.ncbi.nlm.nih.gov/nuccore/PV030920.1, indicated that the ITS identified the species Acidithiobacillus ferrooxidans (Fig : 2).
![]() |
Figure 2: PCR products of the ITS region of Acidithiobacillus ferrooxidans. |
Molecular sequencing confirmed that isolated species was belongs to the Acidithiobacillus ferrooxidans.
Preparation of Bioformulation
![]() |
Figure 3: Mustard seed processing with consortia |
Bioformualtion was prepared with addition of calcium carbonate and carboxy methyl cellulose. After preparation of bioformulation with three bacteria, it was applied to the plantlets of mustard to analyse the vigour index. In that the growth was induced in the treated plantlets (Fig:3).
Plant Tissue Culture for Sugarcane (Saccharum spp.)
Table 2: Callus induction from nodal explants Saccharum officinarum cultured on MS medium supplemented with various concentrations of growth regulators
| Concentrations of Plant Growth Regulations | No. ofexplants inoculated | No.of explants forming callus | Morphology of callus |
| MS + bap 1.5 mg/l + 2,4-D 1.5 mg/l | 20 | 15 ± 0.49 | G, N, F |
| MS + BAP 2.0 mg/l + 2,4-D 2.0 mg/l | 20 | 10 ± 0.99 | G, N, F |
| MS + IAA 1.0 mg/l + BAP 1.0 mg/l | 20 | 5 ± 1.48 | YG, M, F |
| MS + IBA 0.5 mg/l + 2,4-D 0.5 mg/l | 20 | 10 ± 1.48 | YG, M, F |
F = Friable, G = Greenish, M = Massive, N=Nodular, YG = Yellowish Green
![]() |
Figure 4: Friable Callus Induction of Sugarcane |
Table 3: Shoot induction from nodal explants of Saccharum officinarum cultured on MS medium supplemented with various concentrations of growth regulators
| Concentrations of Plant Growth Regulations | No. of explants inoculated | No.of explants produced shoots | No.of shoots developed |
| MS + BAP 3.0 mg/l + Kin 0.5 mg/l +IAA 0.5 mg/l | 20 | 4 ± 0.49 | 1 |
| MS + BAP 3.0 mg/l + Kin 0.5 mg/l + IBA 0.5 mg/l + NAA 0.5 mg/l | 20 | 18 ± 0.49 | 2 |
| MS + BAP 3.0 mg/l + Kin 0.5 mg/l +IBA 0.5 mg/l | 20 | 10 ± 1.48 | 2 |
Value represents means ± SD from 20 ruplicates
Table 4: Root induction from nodal stem explants of Saccharum officinarum cultured on MS medium supplemented with various concentration of growth regulators.
| Concentrations of Plant Growth Regulator | No. of shoot and clones inoculate | No.of clones produced roots | No.of rootsDeveloped |
| MS + IAA 0.5 mg/l + NAA 0.5mg/l + IBA 0.5 mg/l + BAP 1.0 mg/l | 20 | 12 ± 0.99 | 2 |
| MS + IBA 0.5 mg/l + NAA 0.5mg/l + BAP 1.0 mg/l | 20 | 6 ± 0.99 | 2 |
Value represents means ± SD from 20 ruplicates
In tissue culture, the meristem shoot tip culture was done on MS media. The plantlets were yet to grow on media. The heat stress was given to the plantlets by keeping in higher temperature like 40-50 degree heat. After 15 days of observation, the plants survived no physical symptoms happened due to heat stress. This proves that the bioformulation induce abiotic stress tolerance to the paddy plants. It can further used in sugar cane cultivating field for large scale trails.(Fig: 4), (Table: 2), (Table: 3), (Table: 4).
Carbon estimation in both TC and pot culture test plants
Carbon was higher in TC treated bio inoculated plants whereas the estimation found less in pot culture compared to control.
Discussion
The study identifies strain variability, formulation and distribution concerns, regulatory barriers, and socioeconomic constraints as potential obstacles to the widespread use of PGPB 16.
Optimizing bacterial inoculation methods and ensuring bacterial compatibility are also noted as challenges. The use of plant growth-promoting bacteria (PGPB) like Acidithiobacillus, in sugarcane cultivation has shown potential for sustainable production.20 PGPB can enhance plant tolerance to abiotic stress, such as drought, salinity, and heavy metal toxicity, by modulating hormone levels, increasing antioxidant activity, and improving water use efficiency.21 The application of the bacteria may result in synergistic effects, but challenges include optimizing bacterial inoculation methods, ensuring bacterial compatibility, and understanding the mechanisms underlying plant-bacteria interactions.22 Future research should focus on elucidating the specific mechanisms by which these bacteria confer stress tolerance and improve carbon supply in sugarcane, involving molecular and physiological studies. Field trials and large-scale implementation studies are needed to assess the efficacy and economic feasibility of these bacteria in sugarcane cultivation under diverse environmental conditions.
Conclusion
The application of PGPB shows promise for enhancing crop production and sustainability, and continued research and innovation are essential for realizing the full potential of PGPB in agriculture. The study suggests that bioformulation induces abiotic stress tolerance and improves carbon supply in sugarcane. In conclusion, the application of plant growth-promoting bacteria (PGPB) presents a promising avenue for enhancing crop production and sustainability. Despite facing challenges such as strain variability, formulation issues, regulatory barriers, and socio-economic constraints, the potential benefits of PGPB in agriculture cannot be overlooked.23 By leveraging advancements in microbial ecology, genetics, and biotechnology, along with collaborative efforts among researchers, policymakers, and agricultural stakeholders, it is possible to address these challenges and realize the full potential of PGPB in crop production. Moving forward continued research, innovation, and adoption of PGPB-based technologies are essential for overcoming existing limitations and harnessing the benefits of these beneficial microorganisms to meet the increasing demand for food while minimizing environmental impact.
Acknowledgement
We thank TNSCST Government of Tamilnadu for instrumentation facilities provided to the Department of Microbiology, AVS College of Arts and Science (Autonomous), Salem. We also thank Dr. I. Carmel Mercy Priya, Principal and Thiru. K. Rajavinayakam, Secretary AVS College of Arts and Science (Autonomous), Salem.
Funding Sources
The author received no financial support for the research, authorship, and publication of this article.
Conflict of Interest
The authors do not have any conflict of interest.
Data Availability Statement
This statement does not apply to this article.
Ethics Statement
This research did not involve human participants, animal subjects, or any material that requires ethical approval.
Informed Consent Statement
This study did not involve human participants, and therefore, informed consent was not required.
Clinical Trial Registration
This research does not involve any clinical trials.
Permission to reproduce material from other sources
Not Applicable
Authors’ Contribution
Barkathulla Syed Nazeer: Data Collection, Analysis, Writing – Review & Editing.
Vijaya Surya: Visualization, Supervision, Project Administration.
Dheepan George: Methodology, Writing – Original Draft, Visualization, Supervision, Project Administration.
References
- Singh, Rajesh Kumar, Pratiksha, et.al.. Plant-PGPR interaction study of plant growth- promoting diazotrophs Kosakonia radicincitans BA1 and Stenotrophomonas maltophilia COA2 to enhance growth and stress-related gene expression in Saccharum spp.. Journal of Plant 2020;15(1):427-445. doi:https://doi.org/10.1080/17429145.2020.1857857
CrossRef - Chaudhary, Twinkle, Dixit, Mandeep, et . Techniques for improving formulations of bioinoculants. 3 Biotech. 2020;10(5). doi: https://doi.org/10.1007/s13205-020-02182-9
CrossRef - Benbrik, Brahim, Elabed, et al. A phosphocompost amendment enriched with PGPR consortium enhancing plants growth in deficient soil. Communications in Soil Science and Plant 2021;52(11): 1236-1247. doi: https://doi.org/10.1080/00103624.2021.1879121
CrossRef - Singh, Rajesh Kumar, Pratiksha, et al.. Diversity of nitrogen-fixing rhizobacteria associated with sugarcane: a comprehensive study of plant-microbe interactions for growth enhancement in Saccharum spp.. BMC Plant Biology. 2020;20(1). doi:https://doi.org/10.1186/s12870-020-02400-9
CrossRef - Valdés, Jorge, Pedroso, et . Acidithiobacillus ferrooxidans metabolism: from genome sequence to industrial applications. BMC Genomics. 2008;9(1). doi:https://doi.org/10.1186/1471-2164-9-597
CrossRef - Singh, Rajesh Kumar, Pratiksha, et al.. Diversity of nitrogen-fixing rhizobacteria associated with sugarcane: a comprehensive study of plant-microbe interactions for growth enhancement in Saccharum spp.. BMC Plant Biology. 2020;20(1). doi:https://doi.org/10.1186/s12870-020-02400-9
CrossRef - A V, Semenkov. I N, Karpachevsky. A M, Lednev. S A, Koroleva. T V. Morphological and chemical properties of soils within geological complexes affected by sulfuric acid in forest-steppe of the Central Russian Upland (Russia). IOP Conference Series: Earth and Environmental Science. 2021;862(1):012013. doi:https://doi.org/10.1088/1755-1315/862/1/012013
CrossRef - Postgate, J. R.. Differential media for sulphur bacteria. Journal of the Science of Food and Agriculture. 1959;10(12):669-674. doi:https://doi.org/10.1002/jsfa.2740101206
CrossRef - Davis, Kathryn R., Joseph, Shayne J., Janssen, Peter H.. Effects of Growth Medium, Inoculum Size, and Incubation Time on Culturability and Isolation of Soil Bacteria. Applied and Environmental Microbiology. 2005;71(2):826-834. doi:https://doi.org/10.1128/aem.71.2.826-834.2005
CrossRef - Xia, Jin-lan, Zhang, et . Isolation and characterization of acidophilic bacterium from Dongxiangshan Mine in Xinjiang Province, China. Journal of Central South University of Technology. 2010;17(1):50-55. doi:https://doi.org/10.1007/s11771-010-0010-x
CrossRef - Ahmed, Rafique, Anis, Mohammad. Rapid in vitro propagation system through shoot tip cultures of Vitex trifolia L.–an important multipurpose plant of the Pacific traditional Physiology and Molecular Biology of Plants. 2014;20(3):385-392 doi:https://doi.org/10.1007/s12298-014-0233-7
CrossRef - Parnidi, undefined, Murianigrum, M, Ridhawati, A, Wijayanti, K, Machfud, M, Marjani, undefined. Evaluation of the health and sugarcane seed production from the first ratoon cane at various harvest ages. IOP Conference Series: Earth and Environmental Science. 2022;974(1):012006. doi:https://doi.org/10.1088/1755- 1315/974/1/012006
CrossRef - Ahmed, Rafique, Anis, Mohammad. Rapid in vitro propagation system through shoot tip cultures of Vitex trifolia L.–an important multipurpose plant of the Pacific traditional Physiology and Molecular Biology of Plants. 2014;20(3):385-392 doi:https://doi.org/10.1007/s12298-014-0233-7
CrossRef - Chen, Yen-Ming, Huang, et al.. Effects of light intensity and plant growth regulators on callus proliferation and shoot regeneration in the ornamental succulent Haworthia. Botanical Studies. 2019;60(1). doi:https://doi.org/10.1186/s40529-019-0257-y
CrossRef - Ahmed, Rafique, Anis, Mohammad. Rapid in vitro propagation system through shoot tip cultures of Vitex trifolia L.–an important multipurpose plant of the Pacific traditional Physiology and Molecular Biology of Plants. 2014;20(3):385-392. doi:https://doi.org/10.1007/s12298-014-0233-7
CrossRef - Aswini, K., Gopal, N. O., Uthandi, Sivakumar. Optimized culture conditions for bacterial cellulose production by Acetobacter senegalensis BMC Biotechnology. 2020;20(1). doi:https://doi.org/10.1186/s12896-020-00639-6
CrossRef - Bashan, Yoav, Hernandez, et al.. Alginate microbeads as inoculant carriers for plant growth-promoting bacteria. Biology and Fertility of Soils. 2002;35(5):359-368. doi:https://doi.org/10.1007/s00374-002-0481-5
CrossRef - Chaudhary, Twinkle, Dixit, et al.. Techniques for improving formulations of bioinoculants. 3 2020;10(5). doi:https://doi.org/10.1007/s13205-020-02182-9
CrossRef - Walinga, I., Kithome, M., Novozamsky, I., Houba, V. J. G., van der Lee, J. J.. Spectrophotometric determination of organic carbon in soil. Communications in Soil Science and Plant 1992;23(15-16):1935-1944. doi:https://doi.org/10.1080/00103629209368715
CrossRef - Singh, Rajesh Kumar, Pratiksha, et al.. Diversity of nitrogen-fixing rhizobacteria associated with sugarcane: a comprehensive study of plant-microbe interactions for growth enhancement in Saccharum spp.. BMC Plant Biology. 2020;20(1). doi:https://doi.org/10.1186/s12870-020-02400-9
CrossRef - Kaushal, Manoj, Wani, Suhas . Plant-growth-promoting rhizobacteria: drought stress alleviators to ameliorate crop production in drylands. Annals of Microbiology. 2015;66(1):35-42. doi:https://doi.org/10.1007/s13213-015-1112-3
CrossRef - Magallon-Servin, Paola, Antoun, et al.. Designing a multi-species inoculant of phosphate rock-solubilizing bacteria compatible with arbuscular mycorrhizae for plant growth promotion in low-P soil amended with PR. Biology and Fertility of Soils. 2020;56(4):521-536. doi:https://doi.org/10.1007/s00374-020-01452-1
CrossRef - Vejan, Pravin, Khadiran, et . Encapsulation of plant growth promoting Rhizobacteria prospects and potential in agricultural sector: a review. Journal of Plant Nutrition. 2019;42(19):2600-2623. doi:https://doi.org/10.1080/01904167.2019.1659330
CrossRef
Abbreviations List
PGPB- Plant Growth-Promoting Bacteria
NFb- Nitrogen Fixing bacteria
PCR- Polymerase Chain Reaction

This work is licensed under a Creative Commons Attribution 4.0 International License.